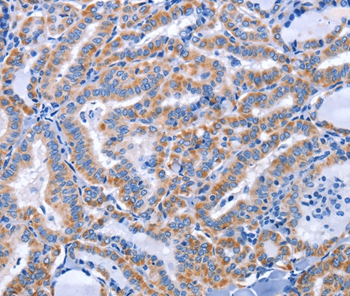
Product Image

Anti-CCR6 Antibody
A38816
ApplicationsWestern Blot, ImmunoHistoChemistry
Product group Antibodies
ReactivityHuman
Overview
- SupplierAntibodies.com
- Product NameAnti-CCR6 Antibody
- Delivery Days Customer7
- ApplicationsWestern Blot, ImmunoHistoChemistry
- CertificationResearch Use Only
- ClonalityPolyclonal
- Concentration2.9 mg/ml
- ConjugateUnconjugated
- HostRabbit
- Scientific DescriptionRabbit polyclonal antibody to CCR6
- ReactivityHuman
- UNSPSC12352203

![Paraformaldehyde-fixed, paraffin embedded human liver cancer; Antigen retrieval by boiling in sodium citrate buffer (pH6) for 15min; Block endogenous peroxidase by 3% hydrogen peroxide for 20 minutes; Blocking buffer (normal goat serum) at 37°C for 30min; Antibody incubation with CCR6 Polyclonal Antibody, Unconjugated (bs-1542R) at 1:200 overnight at 4°C, followed by a conjugated secondary (bs-0295G-AF594) at [1:500] for 90 minutes and DAPI staining of the nuclei.](https://biossantibodies.com/image-raw/12822.jpeg)

